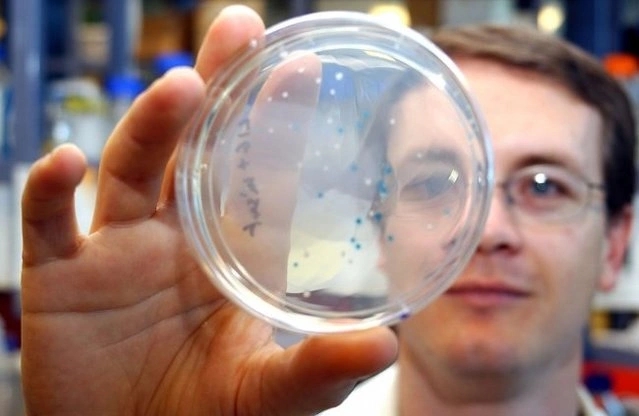
Bacterial spores: the ultimate weapon that is not afraid of even anthrax

The following is the Chinese version optimized for the reading habits of American readers, with cultural adaptability, measurement units, professional terms and reading rhythm adjusted:
Chlorine dioxide disinfectant: "Thanos" in the bacterial world (US version)

Core tips
In the post-epidemic era, American consumers are paying more and more attention to the safety of disinfection in their homes and workplaces. As an FDA-certified high-efficiency disinfectant, chlorine dioxide (ClO₂) has become a star product in the fields of medical care, food processing and water treatment due to its unique advantages. This article will use the "American popular science" style to show you how it can accurately combat various pathogens.
1. Gram-positive bacteria: threats from gyms to refrigerators
(I) Staphylococcus aureus: invisible opponents of fitness enthusiasts
• Common scenes in the United States: gym equipment, school locker rooms, home kitchens
• Hazards: cause skin abscesses (about 30% of community-acquired infections in the United States are caused by it), food poisoning (according to statistics from the US CDC, about 240,000 people are infected each year)
• Chlorine dioxide countermeasures: by destroying the lipid structure of the cell wall (similar to "disassembling Lego blocks"), even MRSA (methicillin-resistant Staphylococcus aureus) cannot escape its effect, which is crucial for American hospitals to fight "super bacteria".

(II) Streptococcus: The culprit from pharyngitis to neonatal crisis
• Group A Streptococcus: The main cause of about 11 million cases of pharyngitis in the United States each year, and may cause scarlet fever (a red rash disease in children)
• Group B Streptococcus: The second largest cause of neonatal sepsis in the United States (second only to E. coli)
• Principle of action: Oxidative attack on bacterial DNA and protein synthesis system (equivalent to destroying the "brain and factory" of bacteria)
(III) Listeria: A fatal hidden danger in American refrigerators
• Special ability: Can reproduce at 4°C (standard temperature of American refrigerators), commonly found in ready-to-eat meat (such as turkey slices) and soft cheese
• High-risk groups: pregnant women (infection may cause miscarriage), people with weakened immunity
• Advantages of chlorine dioxide: Approved by the United States Department of Agriculture (USDA) for disinfection of food contact surfaces, it can effectively penetrate biofilms and kill latent bacteria
(IV) Enterococcus faecalis/Enterococcus faecium: Top 3 antibiotic resistance in American hospitals
• Current status of resistance: Listed as an "urgent threat" pathogen by the US CDC, some strains are resistant to vancomycin
• Infection scenarios: Catheter-associated urinary tract infection (CAUTI), abdominal surgery infection
• Disinfection breakthrough: Chlorine dioxide can bypass the resistance mechanism and directly destroy cell metabolism
II. Gram-negative bacteria: Challenges from tap water to hospitals

(I) Escherichia coli: The number one killer of foodborne diseases in the United States
• Data speaks: There are about 265,000 cases of E. coli infection in the United States each year (CDC data), which is common in undercooked beef and lettuce
• Chlorine dioxide solution: Approved by the US Environmental Protection Agency (EPA) for drinking water disinfection, destroying the cell membrane lipopolysaccharide (LPS) structure
(II) Pseudomonas aeruginosa: A stubborn opponent of the US ICU
• Hospital infection data: Accounting for 10%-20% of ventilator-associated pneumonia (VAP) cases
• Resistance characteristics: The resistance rate to carbapenem antibiotics exceeds 30% (American Hospital Association report)
• Mechanism of action: Oxidative attack on the "energy factory" of bacteria (mitochondrial analogs), blocking ATP synthesis
(III) Vibrio cholerae: The focus of US border epidemic prevention
• Historical lessons: In 1991, Peruvian cholera was introduced to the United States by sea, causing more than 2,000 cases
• Emergency disinfection: The U.S. CDC recommends chlorine dioxide for cruise ship ballast water disinfection
(IV) Salmonella and Shigella: Frequent visitors to U.S. food safety alerts
• Salmonella: About 1.35 million infections in the United States each year (FDA statistics), commonly found in eggs and poultry
• Shigella: The main pathogen of bacterial dysentery in American children
• Application scenarios: Approved by the U.S. Department of Agriculture for washing fresh agricultural products

(V) Legionella: The nightmare of the American Veterans Association
• Outbreak case: The Philadelphia Veterans Convention in 1976 caused 221 infections and 34 deaths
• Prevention and control measures: The U.S. ASHRAE standard requires cooling towers to be regularly treated with chlorine dioxide
(VI) Campylobacter: The risk of "backyard barbecue" in the United States
• Infection route: Undercooked chicken (about 1.3 million infections in the United States each year)
• Disinfection key: Chlorine dioxide can effectively inactivate bacteria in poultry slaughter and processing
3. Bacterial spores: the ultimate weapon that is not afraid of even anthrax
• Comparative data:
Disinfectant Bacillus subtilis killing rate (5 minutes) Chlorine dioxide 99.9% Sodium hypochlorite 85% Alcohol <50%
• Special certification: US EPA registered for high-level disinfection (HLD) of medical equipment
4. Why do Americans choose chlorine dioxide?
(I) Broad spectrum: FDA-certified "full spectrum" coverage
• Fights 15 of the 18 priority pathogens listed by the US CDC
(II) High efficiency and low consumption: cost-optimized for US companies
• Comparative experiment: To achieve the same sterilization effect, the amount of chlorine dioxide used is only 1/3 of that of chlorine preparations

(III) Breakthrough in drug resistance: A solution to the US antibiotic resistance crisis
• Particularly effective against "super bacteria" such as MRSA and VRE
(IV) Biofilm killer: The savior of the US pipeline system
• Can penetrate biofilms (American Water Pipe Association research shows that ordinary disinfectants can only kill 30% of bacteria on the surface)
V. US user guide
Important tips:
For home use, it is recommended to choose EPA-registered products (such as Clorox Total 360)
Medical institutions must follow OSHA concentration standards (usually 50-200ppm)
Food contact surfaces must be rinsed after treatment (FDA stipulates that the residual amount is <0.1ppm)

Shopping tips:
• Look for "USP Grade" certification (United States Pharmacopeia Standard)
• Check whether it has passed ANSI/NSF 60 drinking water treatment certification
Editor's note: Although chlorine dioxide is powerful, the US Environmental Protection Agency (EPA) reminds that improper use may irritate the respiratory tract. It is recommended to refer to the product manual or consult a professional disinfection service company (such as Steri-Clean and other well-known American institutions).